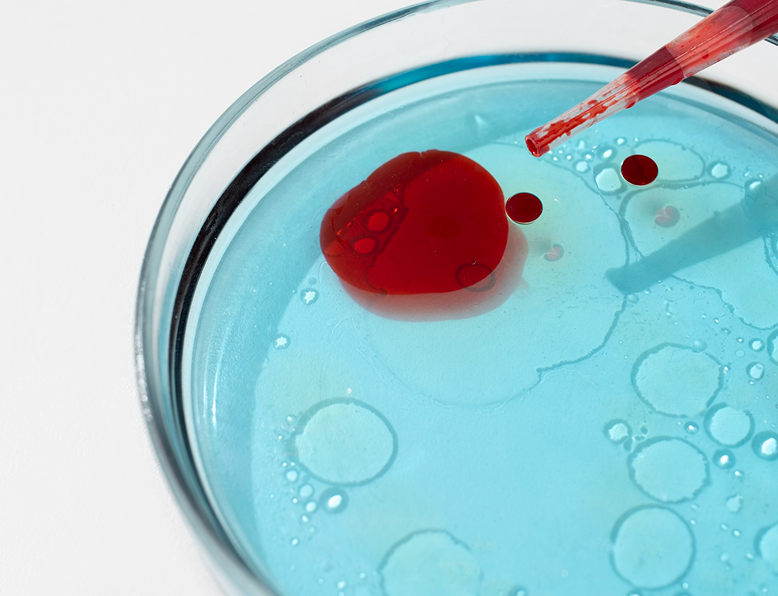
Urology conditions

Urology conditions
Urology Conditions | Consult Experienced Urologist in Dubai
Urology is a specialized branch of medicine that deals with the health of the urinary tract system and male reproductive organs, which includes the kidneys, bladder, ureters, urethra, and genital organs.
Maintaining good urological health is vital for overall wellness, influencing kidney function, bladder control, fertility, and sexual health.
When issues like urinary infections, kidney stones, prostate enlargement, or sexual dysfunction arise, consulting a qualified urologist in Dubai is essential for accurate diagnosis and effective treatment.

Male urology problems and conditions
Men often experience various urological conditions that can affect both their physical health and overall well-being. These conditions may affect the kidneys, bladder, urinary tract, or male reproductive organs — and often require expert evaluation by an experienced urologist in Dubai. Dr. Muthana Alrawi provides specialized, family-centered care for young patients, focusing on comfort and long-term health.
Below are some of the most frequent male urology conditions treated by Dr. Muthana Alrawi:

Kidney or urinary stones are hard mineral deposits that can cause severe pain, nausea, and blood in the urine.
Advanced imaging and minimally invasive treatments like laser lithotripsy and endoscopic stone removal are used for precise, effective management and prevention.

Cancers affecting the kidneys, bladder, prostate, or testes require early detection for successful treatment.
Dr. Muthana Alrawi offers advanced diagnostic and surgical options, including laparoscopic and robotic-assisted surgery, ensuring precision and better outcomes.

Prostate conditions, including Benign Prostatic Hyperplasia (BPH), prostatitis, and prostate cancer, are among the most common male urological problems.
Symptoms like weak urine flow, frequent urination, or pelvic pain often indicate prostate enlargement or inflammation.

While more common in women, men can develop UTIs due to prostate issues, stones, or urinary obstruction.
Symptoms can include burning during urination and cloudy or foul-smelling urine. Prompt antibiotic treatment and addressing the root cause help prevent recurrence.
Kidney or urinary stones are hard mineral deposits that can cause severe pain, nausea, and blood in the urine.
Advanced imaging and minimally invasive treatments like laser lithotripsy and endoscopic stone removal are used for precise, effective management and prevention.

Blood in semen is often caused by inflammation of the prostate, seminal vesicles, or urethra.
While usually benign, persistent cases should be examined to rule out underlying urological conditions.

Loss of bladder control may result from aging, prostate surgery, nerve damage, or infections.
Treatment depends on the underlying cause and may include bladder training, pelvic floor exercises, medications, or minimally invasive urology treatments Dubai.

Pediatric urology addresses urinary and genital issues in children, such as undescended testicles, urinary reflux, bedwetting, or congenital abnormalities.
Dr. Muthana offers specialized care for young patients, ensuring accurate diagnosis and gentle, family-centered treatment.
Causes of urological diseases
Understanding the root cause helps your urologist in Dubai design the most effective treatment plan tailored to your condition.
Aging and Hormonal Changes
Can contribute to prostate enlargement, erectile dysfunction, and bladder issues.
Dehydration and Kidney Stress
Increases the risk of kidney stones and urinary infections.
Obesity and Sedentary Lifestyle
Strains the kidneys and bladder, affecting fertility and urinary control.
Poor Dietary Habits
High salt, processed foods, and low water intake can impact kidney function.
Uncontrolled Diabetes or Hypertension
Can damage the kidneys over time.
Genetic Predisposition
Family history can increase risks of stones, prostate issues, or kidney disease.
Smoking and Alcohol
Harmful to the bladder, kidneys, and overall urological health.
Infections and STDs
Can cause inflammation, scarring, and fertility problems.
Trauma or Surgical Complications
May disrupt urinary flow or cause strictures.
Symptoms of urological diseases
Recognizing the early signs of urological conditions can lead to timely diagnosis and treatment. If you experience any of these symptoms, it’s important to consult a urology specialist Dubai promptly.
Common symptoms include:
Frequent Urination or Urgency
Pain or Burning Sensation During Urination
Blood in Urine (hematuria)
Difficulty Starting or Stopping Urination
Chronic Pain in the Abdomen, Lower Back, or Sides
Weak Urine Flow
Erectile or Sexual Dysfunction
Swelling in the Scrotum or Testicles
Urinary Leakage or Incontinence

Urology tests and procedures
Dr. Muthana Alrawi offers a full range of diagnostic tests to assess urological health and pinpoint the underlying issue. These may include:
- Urinalysis and urine culture
- Blood tests (for kidney function and hormone levels)
- Ultrasound scan or CT imaging
- Cystoscopy (to view inside the bladder and urethra)
- Urodynamic testing (for bladder and urinary flow assessment)
- Prostate-Specific Antigen (PSA) test
- Semen analysis (for fertility evaluation)
Advanced urology treatments Dubai
As a leading urologist in Dubai, Dr. Muthana Alrawi provides both non-surgical and surgical treatments, tailored to each patient’s specific diagnosis. Some of the key urology treatments Dubai offers include:
Medical management
- Medications to help manage symptoms of prostate enlargement, treat urinary tract infections, and improve erectile function.
- Hormone therapy for reproductive or prostate-related issues to help restore normal hormone levels and improves quality of life.
- Pain relief and anti-inflammatory treatments for kidney stones, supporting the body as stones pass naturally or prepare for minimally invasive procedures.
Minimally invasive procedures
- Laser Lithotripsy – Uses precise laser energy to break kidney or ureteral stones into small fragments, allowing them to pass naturally. This method reduces pain, shortens recovery time, and avoids the need for open surgery.
- Urethral Dilation – Gently widens the urethra to relieve urinary obstruction caused by strictures. This minimally invasive approach restores normal urine flow and improves overall comfort.
- Transurethral Resection of the Prostate (TURP) – Endoscopic removal of excess prostate tissue to relieve symptoms of enlargement, such as weak urine flow or frequent urges. It improves urinary function with minimal surgical trauma.
- Rezūm Water Vapor Therapy – A steam-based treatment that reduces excess prostate tissue, relieving urinary symptoms caused by benign prostatic hyperplasia (BPH). Offers a faster recovery and minimal impact on sexual function compared to traditional surgery.
- Shock Wave Therapy & P-Shot – Non-surgical options for erectile dysfunction and penile tissue regeneration. Shock wave therapy promotes natural blood flow and tissue healing, while the P-Shot uses platelet-rich plasma to enhance sensitivity and erectile function.
Advanced surgical procedures
- Laparoscopic & Robotic-Assisted Surgery – Precise removal of tumors or diseased tissue in the kidneys, bladder, or prostate through minimal incisions. Robotic assistance increases surgical precision, reduces recovery time, and enhances outcomes.
- Percutaneous Nephrolithotomy (PCNL) – Minimally invasive surgery for large or complex kidney stones. Stones are removed directly through a small incision in the back, reducing pain and shortening hospital stay.
- Microsurgical Varicocele Ligation – Corrects varicoceles, improving blood flow and enhancing male fertility. The microsurgical approach ensures precision, minimal complications, and faster recovery.
- Micro Testicular Sperm Extraction (microTESE) – Specialized procedure to retrieve sperm in cases of male infertility. It is performed under magnification to maximize success while preserving healthy testicular tissue.
- Penile Implants & Augmentation Surgery – Surgical solutions for erectile dysfunction and penile enhancement. These procedures restore function and confidence, offering long-term results with carefully planned surgical techniques.
Tips to improve your urological health
Maintaining good urological health involves simple yet impactful lifestyle habits:
Stay hydrated — drink plenty of water daily.
Limit caffeine, alcohol, and sugary beverages.
Maintain a healthy weight and exercise regularly.
Avoid smoking and processed foods.
Manage blood sugar and blood pressure levels.
Don’t delay urination when you feel the urge.
Practice safe sex and regular health checkups.
Schedule routine prostate and kidney screenings, especially after age 40.
Why choose Dr. Muthana Alrawi, the leading urologist in Dubai?
- Renowned expertise – 20 Years of clinical experience in advanced urology treatments Dubai.
- Personalized care – Tailored diagnosis and management for every patient.
- Advanced technology – Access to state-of-the-art diagnostic and surgical equipment.
- Patient-centered approach – Compassionate communication and privacy at every step.
- Proven results – High success rates and long-term health outcomes.
Whether you’re dealing with kidney stones, prostate issues, or fertility concerns, Dr. Muthana Alrawi offers trusted, world-class care designed for your comfort and confidence.
FAQs
You should visit a urologist if you have trouble urinating, persistent pain, blood in urine, or sexual or fertility issues. Early consultation helps prevent complications and ensures timely treatment.
Most modern urology treatments are minimally invasive, with little to no discomfort and quick recovery times.
Yes. Adopting healthy habits like staying hydrated, maintaining a balanced diet, exercising regularly, and managing chronic conditions can greatly reduce the risk of developing urological issues.
Prostate issues may present as frequent urination, difficulty starting or stopping urination, weak or interrupted urine flow, or pelvic discomfort. Men experiencing these signs should consult a male urology Dubai specialist without delay.
Men aged 40 and above are recommended to undergo yearly prostate screenings to identify early signs of enlargement or prostate cancer, allowing for timely and effective treatment.

